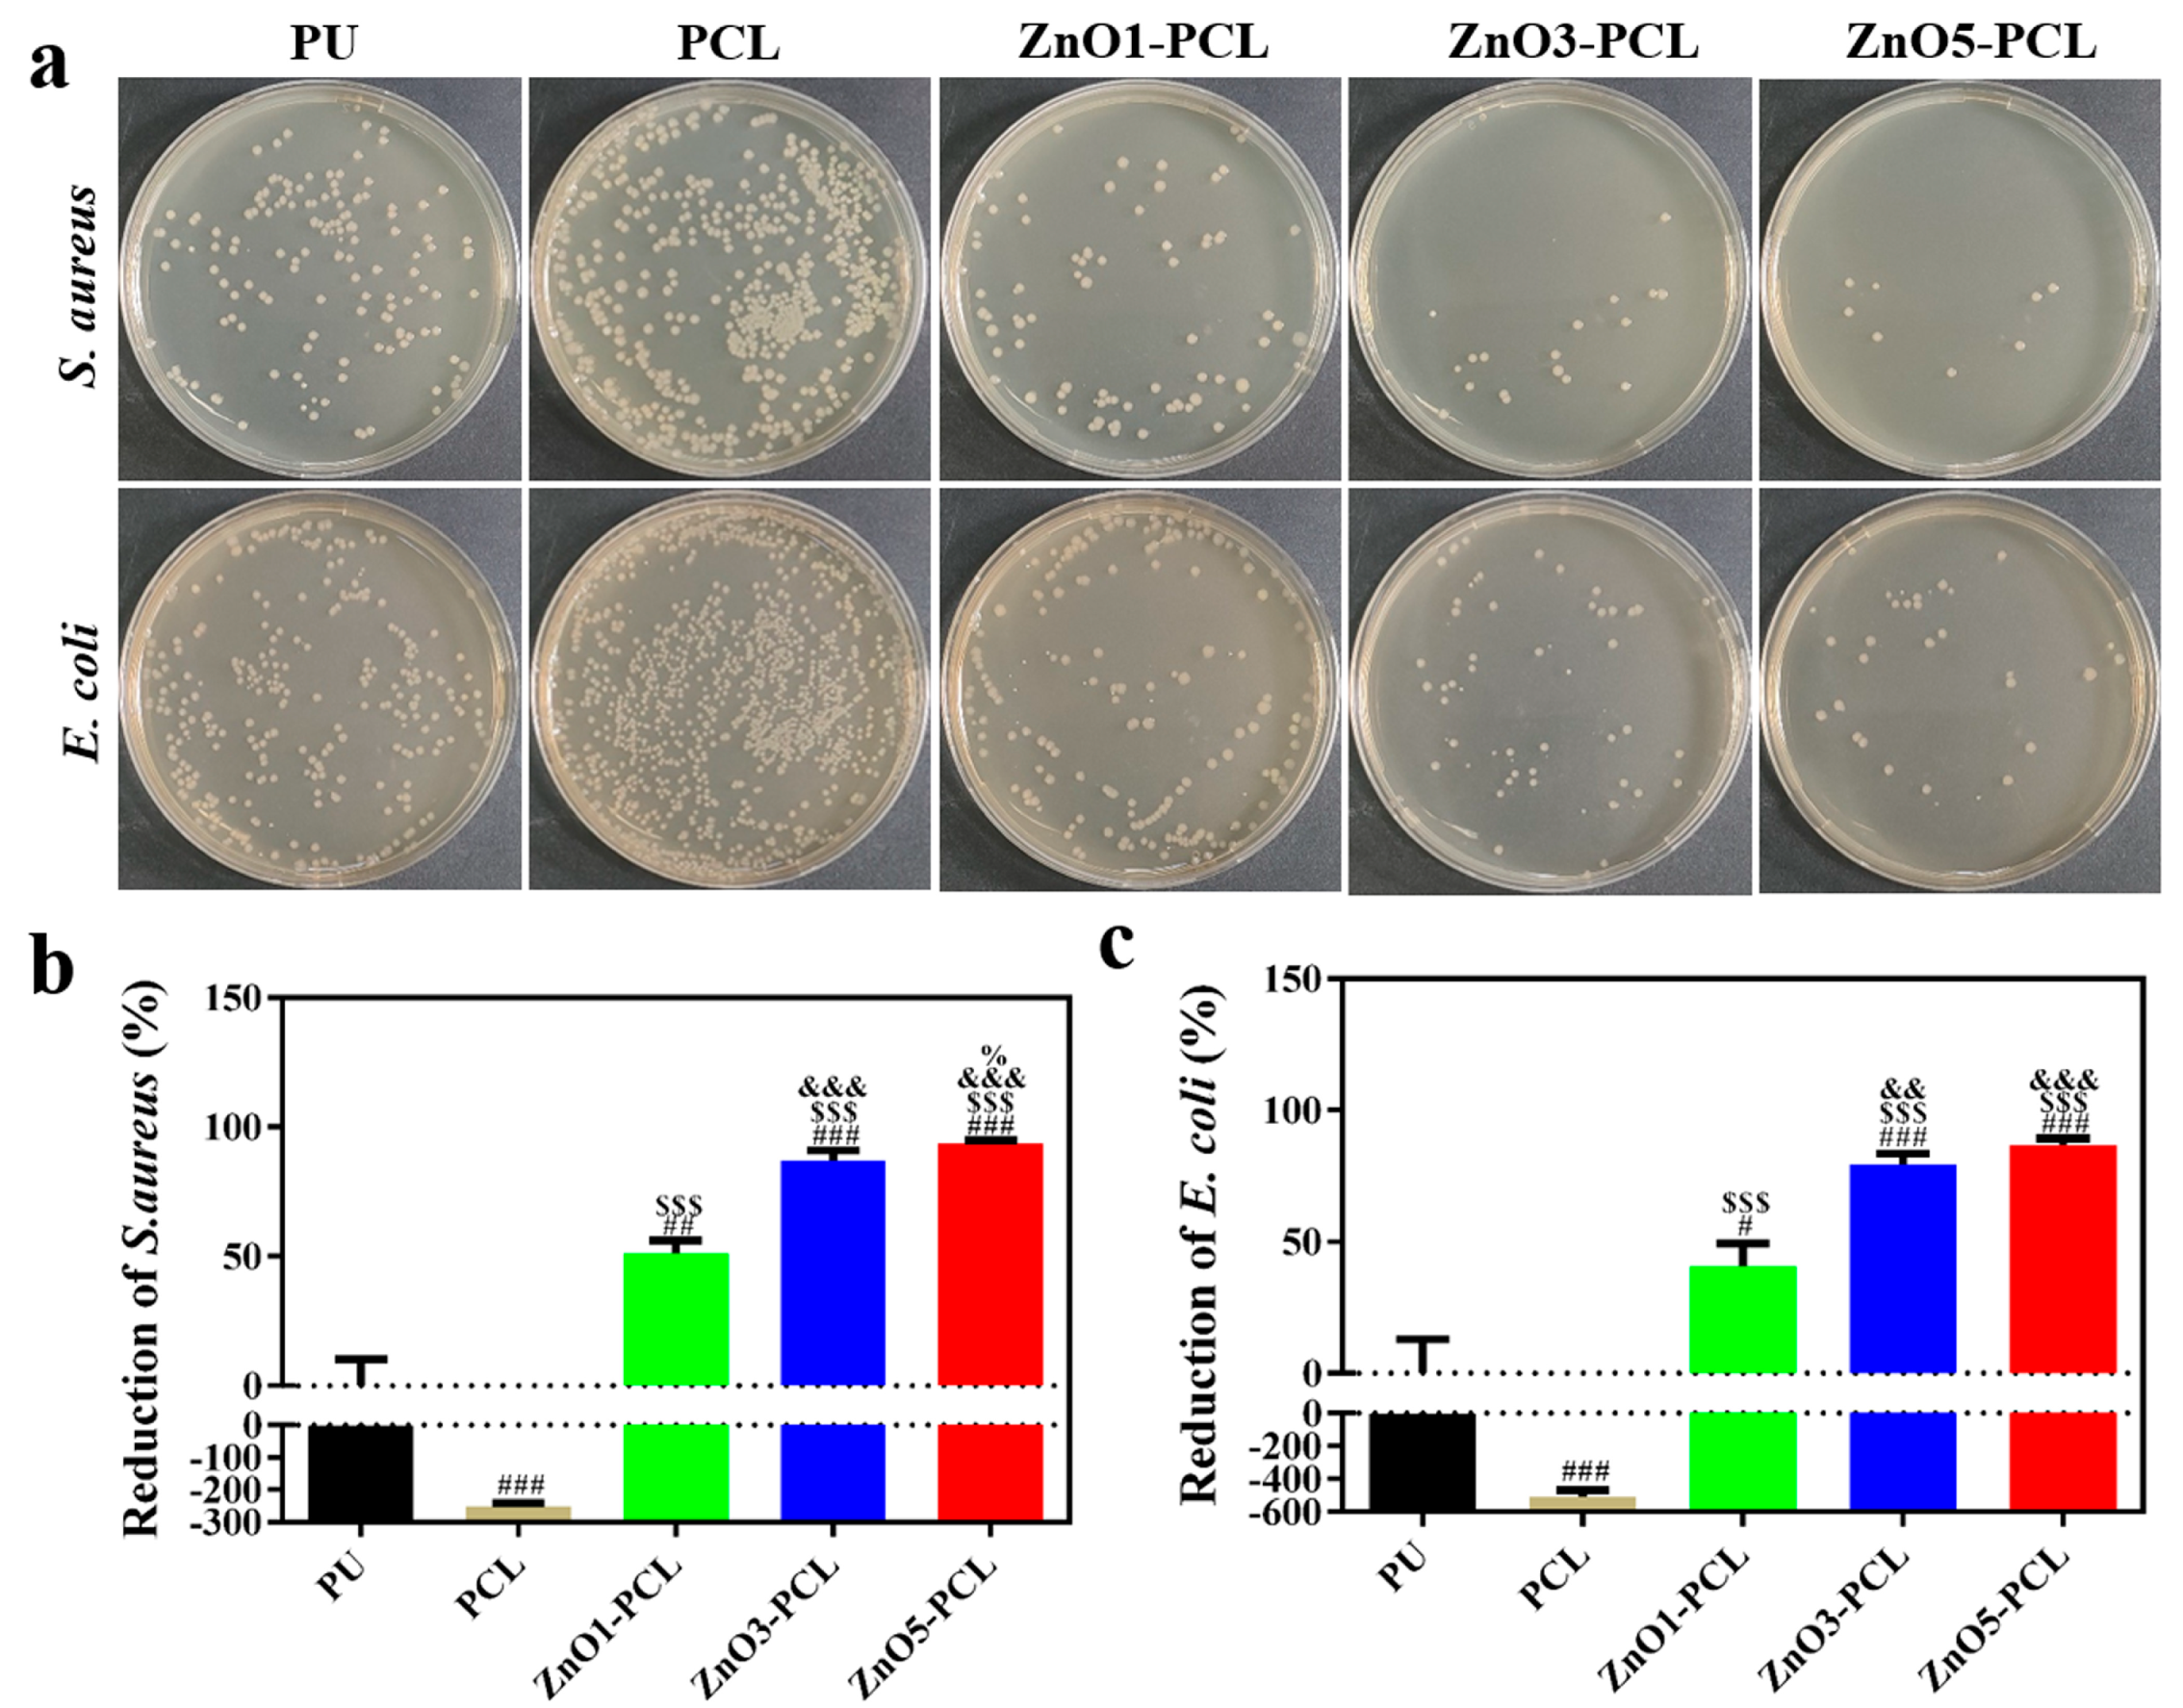
Jfb 14 00225 g003 Jfb 14 00225 g003

Construction of ZnO/PCL Antibacterial Coating Potentially for Dental Unit Waterlines
Abstract
1. Introduction
2. Materials and Methods
2.1. Sample Preparation
2.2. Surface Characterization
2.3. Antibacterial Properties Evaluation In Vitro
2.4. Cell Compatibility Assessment
2.5. Statistical Analysis
3. Results and Discussion
3.1. Surface Characterization
3.2. Antibacterial Activity In Vitro
3.3. Cell Compatibility In Vitro
4. Conclusions
Author Contributions
Funding
Data Availability Statement
Conflicts of Interest
References
- Coleman, D.C.; O’Donnell, M.J.; Shore, A.C.; Russell, R.J. Biofilm problems in dental unit water systems and its practical control. J. Appl. Microbiol. 2009, 106, 1424–1437. [Google Scholar] [CrossRef] [PubMed]
- Barbeau, J.; Tanguay, R.; Faucher, E.; Avezard, C.; Trudel, L.; Cote, L.; Prevost, A.P. Multiparametric analysis of waterline contamination in dental units. Appl. Environ. Microb. 1996, 62, 3954–3959. [Google Scholar] [CrossRef] [PubMed]
- Mazari, W.; Boucherit-Otmani, Z.; El Haci, I.A.; Ilahi, A.; Boucherit, K. Risk assessment for the spread of Candida sp. in dental chair unit waterlines using molecular techniques. Int. Dent. J. 2018, 68, 386–392. [Google Scholar] [CrossRef] [PubMed]
- O’Donnell, M.J.; Boyle, M.A.; Russell, R.J.; Coleman, D.C. Management of dental unit waterline biofilms in the 21st century. Future Microbiol. 2011, 6, 1209–1226. [Google Scholar] [CrossRef] [PubMed]
- Garg, S.K.; Mittal, S.; Kaur, P. Dental unit waterline management: Historical perspectives and current trends. J. Investig. Clin. Dent. 2012, 3, 247–252. [Google Scholar] [CrossRef]
- Ji, X.Y.; Fei, C.N.; Zhang, Y.; Liu, J.; Liu, H.; Song, J. Three key factors influencing the bacterial contamination of dental unit waterlines: A 6-year survey from 2012 to 2017. Int. Dent. J. 2019, 69, 192–199. [Google Scholar] [CrossRef]
- Ozawa, T.; Nakano, M.; Arai, T. In vitro study of anti-suck-back ability by themselves on new high-speed air turbine handpieces. Dent. Mater. J. 2010, 29, 649–654. [Google Scholar] [CrossRef]
- Wirthlin, M.R.; Marshall, G.W.; Rowland, R.W. Formation and Decontamination of Biofilms in Dental Unit Waterlines. J. Periodontol. 2003, 74, 1595–1609. [Google Scholar] [CrossRef]
- Walker, R.J.; F.Burke, J.T.; Miller, C.H.; Palenik, C.J. An investigation of the microbial contamination of dental unit air and water lines. Int. Dent. J. 2004, 54, 438–444. [Google Scholar] [CrossRef]
- Putnins, E.E.; Giovanni, D.D.; Bhullar, A.S. Dental Unit Waterline Contamination and Its Possible Implications during Periodontal Surgery. J. Periodontol. 2001, 72, 393–400. [Google Scholar] [CrossRef]
- Shajahan, I.F.; Kandaswamy, D.; Srikanth, P.; Narayana, L.L.; Selvarajan, R. Dental unit waterlines disinfection using hypochlorous acid-based disinfectant. J. Conserv. Dent. 2016, 19, 347–350. [Google Scholar] [CrossRef]
- Saidin, S.; Jumat, M.A.; Mohd Amin, N.A.A.; Saleh Al-Hammadi, A.S. Organic and inorganic antibacterial approaches in combating bacterial infection for biomedical application. Mater. Sci. Eng. C 2021, 118, 111382. [Google Scholar] [CrossRef]
- Hong, F.; Chen, P.; Yu, X.; Chen, Q. The Application of Silver to Decontaminate Dental Unit Waterlines—A Systematic Review. Biol. Trace Elem Res. 2022, 200, 4988–5002. [Google Scholar] [CrossRef]
- Kolmas, J.; Groszyk, E.; Kwiatkowska-Różycka, D. Substituted Hydroxyapatites with Antibacterial Properties. BioMed Res. Int. 2014, 2014, 178123. [Google Scholar] [CrossRef]
- Chen, X.; Tang, Q.L.; Zhu, Y.J.; Zhu, C.L.; Feng, X.P. Synthesis and antibacterial property of zinc loaded hydroxyapatite nanorods. Mater. Lett. 2012, 89, 233–235. [Google Scholar] [CrossRef]
- Wang, M.Y.; Gao, J.Y. Atomic layer deposition of ZnO thin film on ZrO2 dental implant surface for enhanced antibacterial and bioactive performance. Mater. Lett. 2021, 285, 128854. [Google Scholar] [CrossRef]
- Veselova, V.O.; Plyuta, V.A.; Kostrov, A.N.; Vtyurina, D.N.; Abramov, V.O.; Abramova, A.V.; Voitov, Y.I.; Padiy, D.A.; Thu, V.T.H.; Hue, L.T.; et al. Long-Term Antimicrobial Performance of Textiles Coated with ZnO and TiO2 Nanoparticles in a Tropical Climate. J. Funct. Biomater. 2022, 13, 233. [Google Scholar] [CrossRef]
- Zhang, X.; Shi, H.X.; Liu, E.Z.; Hu, X.Y.; Zhang, K.; Fan, J. Preparation of polycrystalline ZnO nanoparticles loaded onto graphene oxide and their antibacterial properties. Mater. Today Commun. 2021, 28, 102531. [Google Scholar] [CrossRef]
- Qu, H.H.; Wang, C.; Guo, Y.X.; Zhao, Z.Y.; Qiao, L.; Yang, J.B.; Wu, H.X.; Li, Q.S.; Dong, A. Electrospun N-halamine/ZnO-based platform eradicates bacteria through multimodal antimicrobial mechanism of action. Rare Met. 2023, 42, 222–233. [Google Scholar] [CrossRef]
- Ye, K.; Huang, M.; He, X.J.; An, Z.Q.; Qin, H. Synergistic Antibacterial Effect of Zinc Oxide Nanoparticles and Polymorphonuclear Neutrophils. J. Funct. Biomater. 2022, 13, 35. [Google Scholar] [CrossRef]
- Puspasari, V.; Ridhova, A.; Hermawan, A.; Amal1, M.I.; Khan, M.M. ZnO-based antimicrobial coatings for biomedical applications. Bioprocess Biosyst. Eng. 2022, 45, 1421–1445. [Google Scholar] [CrossRef] [PubMed]
- Zhang, X.M.; Qiu, J.J.; Tan, J.; Zhang, D.D.; Wu, L.; Qiao, Y.Q.; Wang, G.C.; Wu, J.; Yeung, K.W.K.; Liu, X.Y. In-situ growth of vertical graphene on titanium by PECVD for rapid sterilization under near-infrared light. Carbon 2022, 192, 209–218. [Google Scholar] [CrossRef]
- Ramalingam, K.; Frohlich, N.C.; Lee, V.A. Effect of nanoemulsion on dental unit waterline biofilm. J. Dent. Sci 2013, 8, 333–336. [Google Scholar] [CrossRef]
- Liu, J.; Wang, P.; Qu, W.; Li, H.; Shi, L.; Zhang, D. Nanodiamond-decorated ZnO catalysts with enhanced photocorrosion-resistance for photocatalytic degradation of gaseous toluene. Appl. Catal. B Environ. 2019, 257, 117880. [Google Scholar] [CrossRef]
- Yang, K.; Shi, J.; Wang, L.; Chen, Y.; Liang, C.; Yang, L.; Wang, L.N. Bacterial anti-adhesion surface design: Surface patterning, roughness and wettability: A review. J. Mater. Sci. Technol. 2022, 99, 82–100. [Google Scholar] [CrossRef]
- Costa, D.; Girardot, M.; Bertaux, J.; Verdon, J.; Imbert, C. Efficacy of dental unit waterlines disinfectants on a polymicrobial biofilm. Water Res. 2016, 91, 38–44. [Google Scholar] [CrossRef]
- Vestby, L.K.; Grønseth, T.; Simm, R.; Nesse, L.L. Bacterial Biofilm and its Role in the Pathogenesis of Disease. Antibiotics 2020, 9, 59. [Google Scholar] [CrossRef]
- Zhu, C.P.; Hong, F.R.; Yu, X.F. Anti-biofilm effect of low concentration chlorine-containing disinfectant assisted by multi enzyme detergent in dental unit waterlines. New Microbiol. 2021, 44, 117–124. [Google Scholar]
- Karpay, R.I.; Plamondon, T.J.; Mills, S.E.; Dove, S.B. Combining periodic and continuous sodium hypochlorite treatment to control biofilms in dental unit water systems. J. Am. Dent. Assoc. 1999, 130, 957–965. [Google Scholar] [CrossRef]
- Wu, M.T.; Shi, Z.W.; Yu, X.F.; Xu, Y.D.; Jin, X.Y.; Zhang, L.; Fu, B.P. Disinfection methods of dental unit waterlines contamination: A systematic review. J. Med. Microbiol. 2022, 71, 001540. [Google Scholar] [CrossRef]
- Zhang, W.; Onyango, O.; Lin, Z.; Lee, S.S.; Li, Y.M. Evaluation of sterilox for controlling microbial biofilm contamination of dental water. Compend. Contin. Educ. Dent. 2007, 28, 590–592. [Google Scholar]
- Pawar, A.; Garg, S.; Mehta, S.; Dang, R. Breaking the chain of infection: Dental unit water quality control. J. Clin. Diagn. Res. 2016, 10, ZC80–ZC84. [Google Scholar] [CrossRef]
- Schel, A.J.; Marsh, P.D.; Bradshaw, D.J.; Finney, M.; Fulford, M.R.; Frandsen, E.; Østergaard, E.; ten Cate, J.M.; Moorer, W.R.; Mavridou, A.; et al. Comparison of the efficacies of disinfectants to control microbial contamination in dental unit water systems in general dental practices across the European Union. Appl. Environ. Microbiol. 2006, 72, 1380–1387. [Google Scholar] [CrossRef]
- Pareek, S.; Nagaraj, A.; Sharma, P.; Atri, M.; Walia, S.; Naidu, S.; Yousuf, A. Disinfection of Dental Unit Water Line Using Aloe Vera: In Vitro Study. Int. J. Dent. 2013, 2013, 618962. [Google Scholar] [CrossRef]

| Samples | Zn Ions Concentration (μg/mL) |
|---|---|
| ZnO1-PCL | 28.4 |
| ZnO3-PCL | 82.2 |
| ZnO5-PCL | 147.8 |
Disclaimer/Publisher’s Note: The statements, opinions and data contained in all publications are solely those of the individual author(s) and contributor(s) and not of MDPI and/or the editor(s). MDPI and/or the editor(s) disclaim responsibility for any injury to people or property resulting from any ideas, methods, instructions or products referred to in the content. |
© 2023 by the authors. Licensee MDPI, Basel, Switzerland. This article is an open access article distributed under the terms and conditions of the Creative Commons Attribution (CC BY) license (https://creativecommons.org/licenses/by/4.0/).
Share and Cite
Xing, M.; Zhang, H.; Zhang, L.; Qian, W. Construction of ZnO/PCL Antibacterial Coating Potentially for Dental Unit Waterlines. J. Funct. Biomater. 2023, 14, 225. https://doi.org/10.3390/jfb14040225
Xing M, Zhang H, Zhang L, Qian W. Construction of ZnO/PCL Antibacterial Coating Potentially for Dental Unit Waterlines. Journal of Functional Biomaterials. 2023; 14(4):225. https://doi.org/10.3390/jfb14040225
Chicago/Turabian StyleXing, Min, Haifeng Zhang, Ling Zhang, and Wenhao Qian. 2023. "Construction of ZnO/PCL Antibacterial Coating Potentially for Dental Unit Waterlines" Journal of Functional Biomaterials 14, no. 4: 225. https://doi.org/10.3390/jfb14040225
APA StyleXing, M., Zhang, H., Zhang, L., & Qian, W. (2023). Construction of ZnO/PCL Antibacterial Coating Potentially for Dental Unit Waterlines. Journal of Functional Biomaterials, 14(4), 225. https://doi.org/10.3390/jfb14040225
